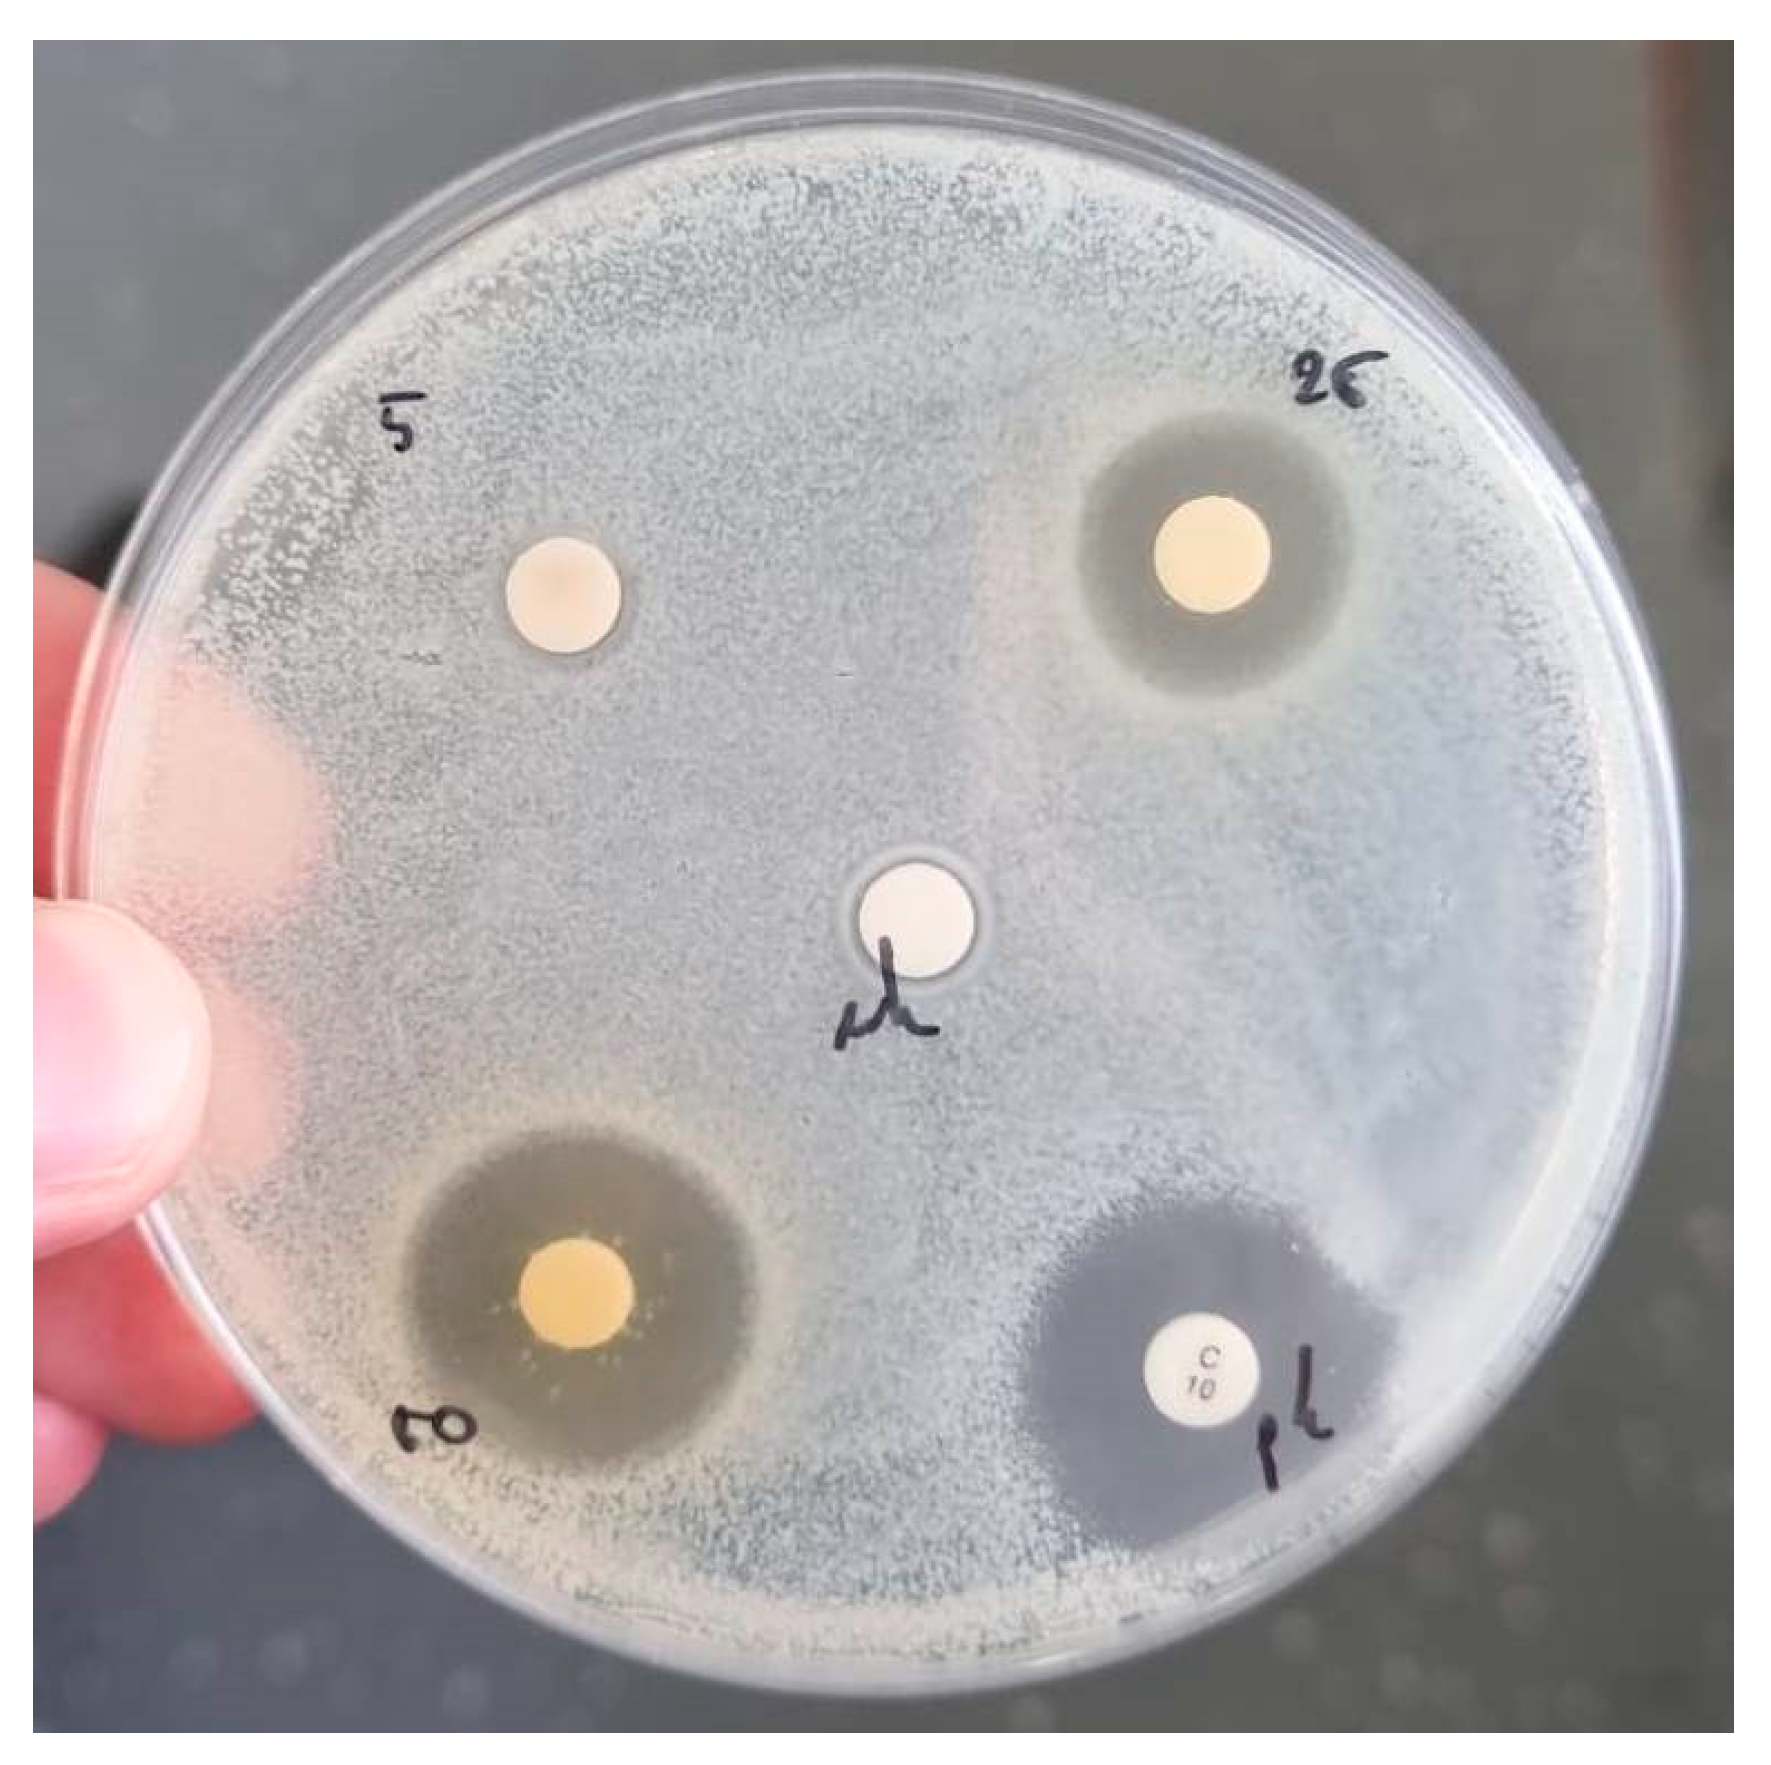
Antioxidants 12 01796 g0a1
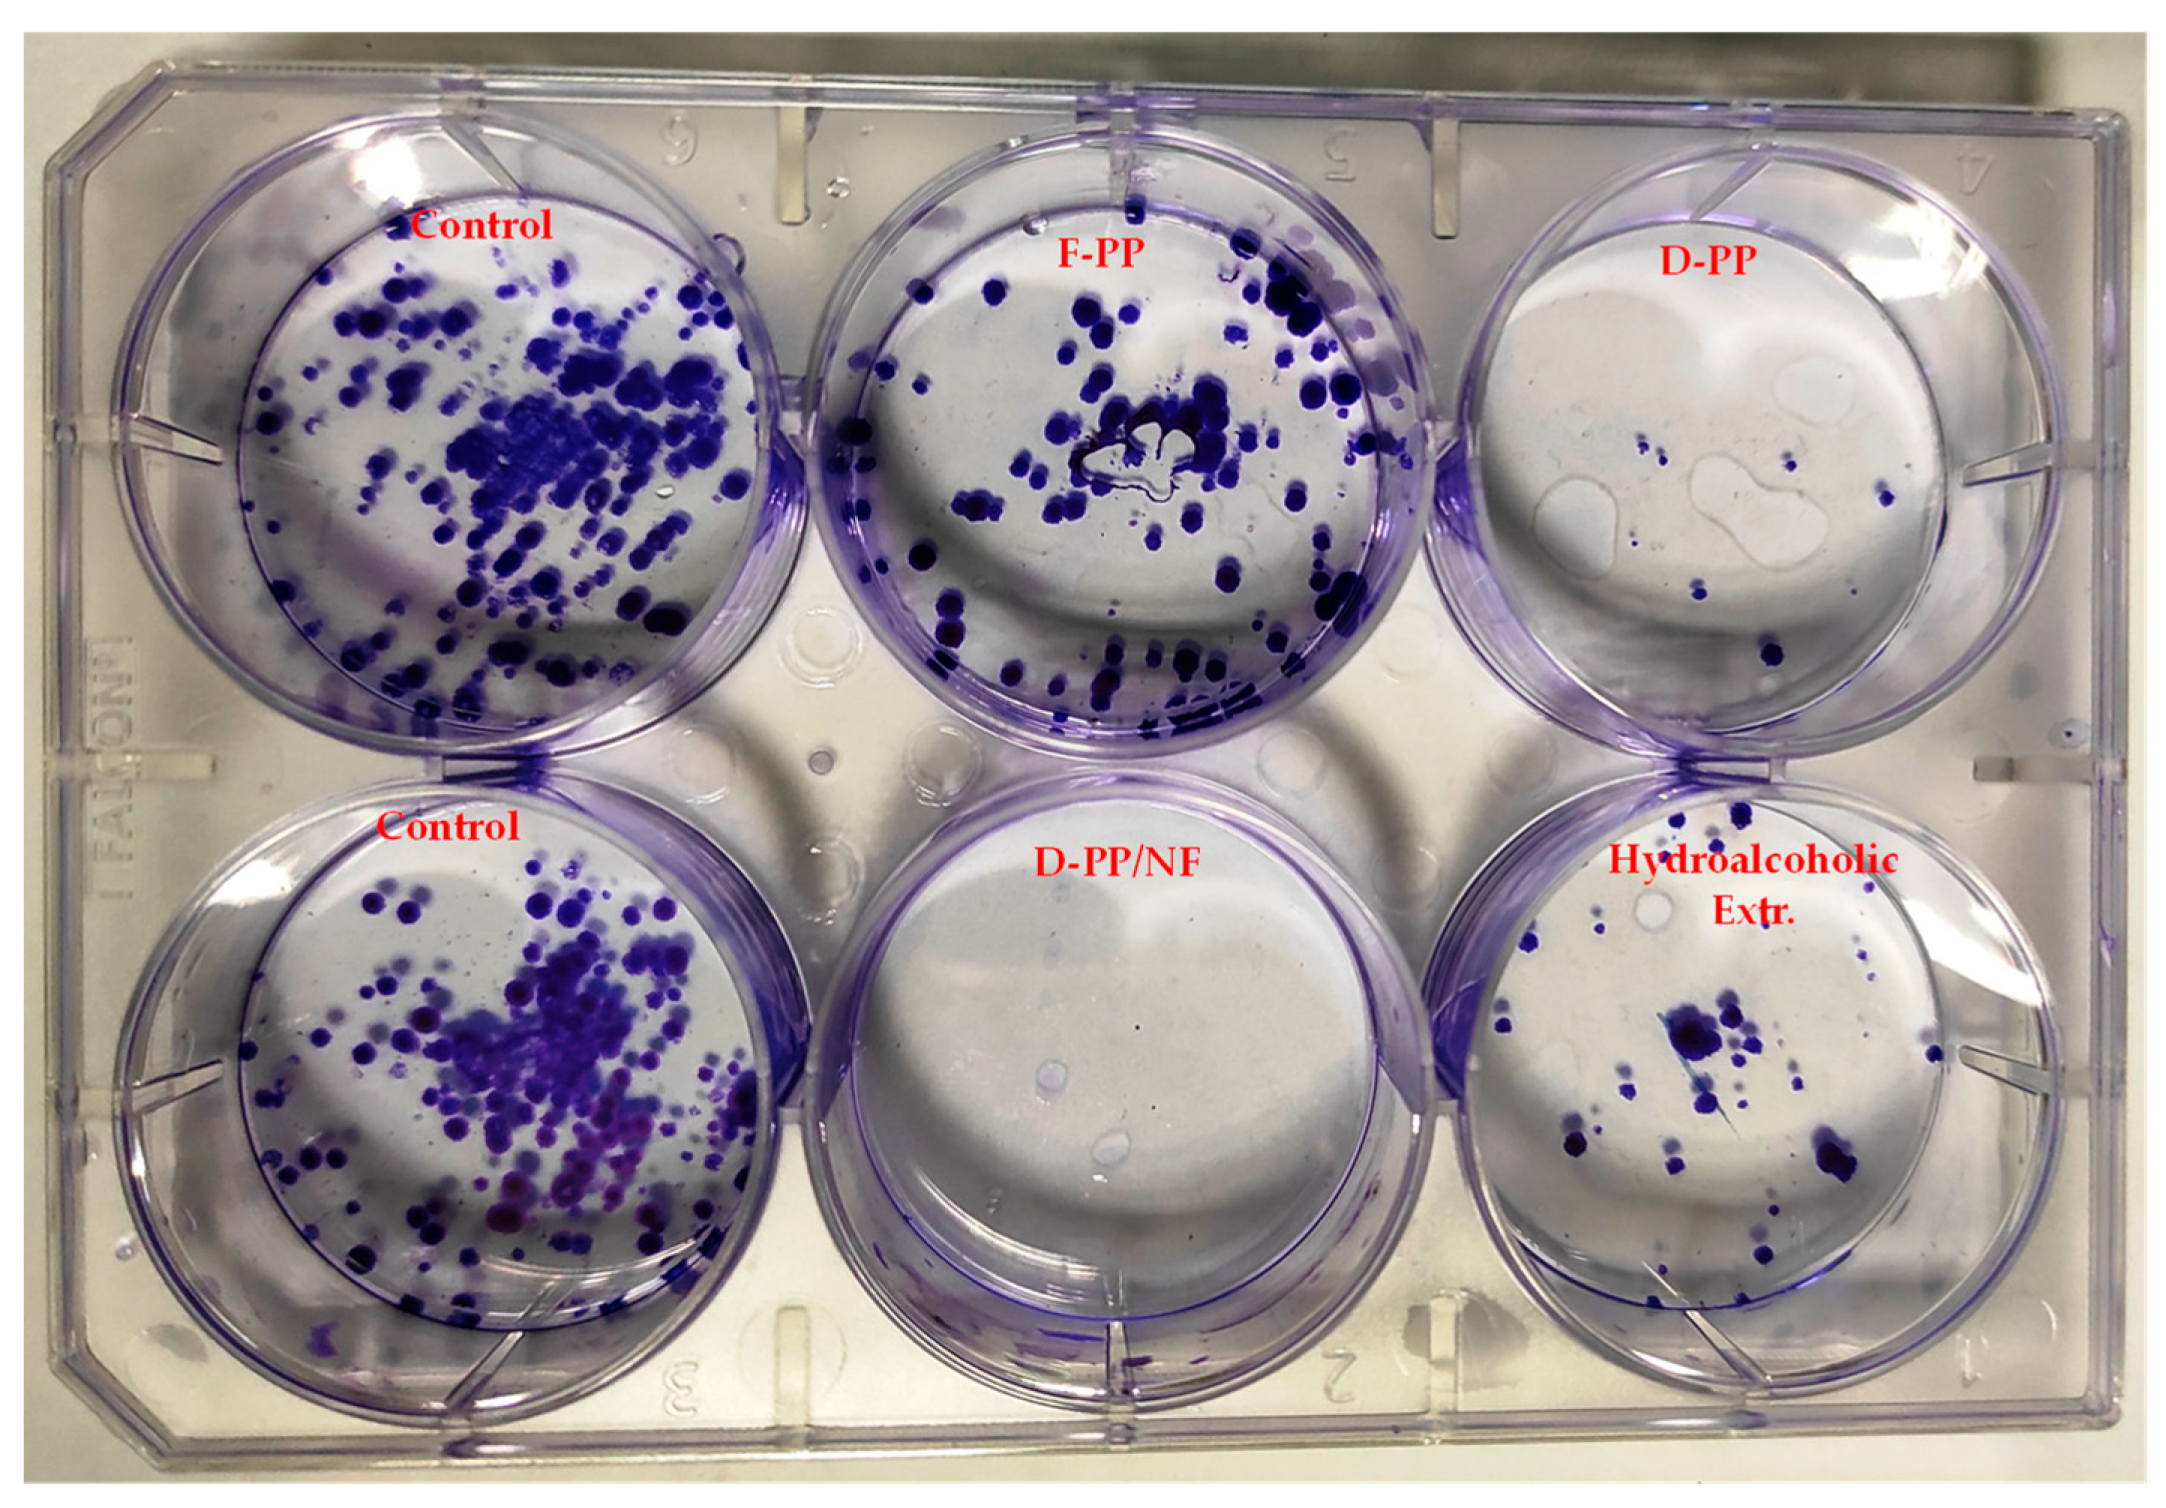
Antioxidants 12 01796 g011

Unlocking the Bioactive Potential of Pomegranate Peels: A Green Extraction Approach
Abstract
:1. Introduction
2. Materials and Methods
2.1. Pomegranate Peels and Chemicals
2.2. MW-Assisted Extraction (MAE) of Pomegranate Peels in Water
2.3. Hydroalcoholic Extraction of Pomegranate Peels
2.4. Membrane Nanofiltration (NF) for Bioactives Concentration and Water Recovery
2.5. Colorimetric Tests on Pomegranate Peel Extracts: Quali-Quantitative Characterisation
2.5.1. Total Phenolic Content (TPC)
2.5.2. Total Anthocyanin Content (TAC)
2.5.3. Total Tannin Content (TTC)
2.5.4. Total Flavonoid Content (TFC)
2.5.5. Total Sugar Content (TSC)
2.5.6. Antioxidant Activity: DPPH· Inhibition
2.5.7. Cu Chelating Activity of PP Extracts
2.6. Biological Activities
2.6.1. Antibacterial Activity Test
2.6.2. Antiproliferation Assay on Human Cell Line
2.6.3. Clonogenic Analysis
2.7. Green Metrics
3. Results and Discussion
3.1. MW-Assisted Extraction of Pomegranate Peels (PP): Lab-Scale
3.1.1. Dry Yield and Total Phenolic Content (TPC)
3.1.2. Total Anthocyanin Content (TAC)
3.2. MW-Assisted Extraction of Pomegranate Peels (PP): Scale-Up
3.2.1. Extract Characterisation
3.2.2. Fresh and Dried Pomegranate Peels: Power Consumption
3.2.3. Nanofiltration: Water Recovery and Metabolite Concentration
3.3. Biological Activities of PP Extracts
3.3.1. Antibacterial Activity of PP Extracts
3.3.2. Antiproliferative Activity of PP Extracts
3.4. Green Metrics and Power Consumption of Extraction: A Preliminary Evaluation
4. Conclusions
Author Contributions
Funding
Data Availability Statement
Acknowledgments
Conflicts of Interest
Appendix A
| Matrix | t (min) | T (°C) | Dry Yield (%) | S.D. (%) | |
|---|---|---|---|---|---|
| Fresh | 10 | 100 | 20.18 | ± | 0.37 |
| 20 | 22.19 | ± | 0.56 | ||
| 30 | 21.38 | ± | 0.60 | ||
| 10 | 125 | 22.38 | ± | 0.71 | |
| 20 | 22.39 | ± | 0.42 | ||
| 30 | 21.49 | ± | 0.74 | ||
| 10 | 150 | 22.71 | ± | 0.58 | |
| 20 | 23.52 | ± | 0.31 | ||
| 30 | 26.40 | ± | 0.85 | ||
| Dried | 10 | 100 | 67.20 | ± | 0.79 |
| 20 | 67.40 | ± | 1.14 | ||
| 30 | 65.00 | ± | 1.19 | ||
| 10 | 125 | 68.99 | ± | 0.82 | |
| 20 | 75.57 | ± | 0.78 | ||
| 30 | 74.80 | ± | 1.00 | ||
| 10 | 150 | 73.43 | ± | 0.98 | |
| 20 | 73.79 | ± | 0.83 | ||
| 30 | 74.85 | ± | 1.48 | ||
| Conc. | S. typhimurium | S.D. | P. aeruginosa | S.D. | E. coli | S.D. | S. aureus | S.D. | L. monocytogenes | S.D. | B. subtilis | S.D. | |
|---|---|---|---|---|---|---|---|---|---|---|---|---|---|
| (µg/mL) | |||||||||||||
| F-PP | 50 | 9.7 | 0.6 | 0 | 0 | 0 | 0 | 0 | 0 | 0 | 0 | 0 | 0 |
| 250 | 12 | 0.6 | 12 | 0.6 | 8 | 2.1 | 15 | 0.6 | 0 | 0 | 0 | 0 | |
| 500 | 16 | 1.5 | 14 | 1 | 16 | 1.5 | 22 | 1.2 | 0 | 0 | 0 | 0 | |
| pc | 22 | 1.2 | 16 | 1.2 | 23 | 0.6 | 19 | 1 | 17 | 0 | 16 | 1.2 | |
| nc | 0 | 0 | 0 | 0 | 0 | 0 | 0 | 0 | 0 | 0 | 0 | 0 | |
| D-PP | 50 | 0 | 0 | 0 | 0 | 0 | 0 | 0 | 0 | 0 | 0 | 0 | 0 |
| 250 | 12 | 0 | 11 | 1.2 | 15 | 3.1 | 15 | 0.6 | 0 | 0 | 0 | 0 | |
| 500 | 15 | 1.2 | 15 | 2.1 | 19 | 1.2 | 22 | 1.2 | 0 | 0 | 0 | 0 | |
| pc | 18 | 3.5 | 11 | 1.2 | 20 | 1 | 19 | 1 | 16 | 2.5 | 17 | 0 | |
| nc | 0 | 0 | 0 | 0 | 0 | 0 | 0 | 0 | 0 | 0 | 0 | 0 | |
| D-PP/NF | 50 | 0 | 0 | 0 | 0 | 0 | 0 | 0 | 0 | 0 | 0 | 0 | 0 |
| 250 | 13 | 0 | 13 | 1.2 | 12 | 1 | 16 | 0.7 | 0 | 0 | 0 | 0 | |
| 500 | 14 | 0.6 | 15 | 1.2 | 16 | 2.1 | 22 | 1.2 | 0 | 0 | 0 | 0 | |
| pc | 18 | 0.6 | 14 | 1 | 21 | 1 | 16 | 0.6 | 15 | 0.6 | 16 | 1 | |
| nc | 0 | 0 | 0 | 0 | 0 | 0 | 0 | 0 | 0 | 0 | 0 | 0 | |
| Hydroalcoholic Extract | 50 | 0 | 0 | 0 | 0 | 0 | 0 | 0 | 0 | 0 | 0 | 0 | 0 |
| 250 | 13 | 0.6 | 14 | 0 | 13 | 1.2 | 15 | 0.6 | 0 | 0 | 0 | 0 | |
| 500 | 17 | 1 | 18 | 0.6 | 18 | 1.5 | 21 | 0.6 | 0 | 0 | 0 | 0 | |
| pc | 20 | 1 | 14 | 2.1 | 20 | 0 | 17 | 1 | 14 | 1.5 | 12 | 0.6 | |
| nc | 0 | 0 | 0 | 0 | 0 | 0 | 0 | 0 | 0 | 0 | 0 | 0 |
References
- FAO. Technical Platform on the Measurement and Reduction of Food Loss and Waste. 2022. Available online: https://www.fao.org/platform-food-loss-waste/en/ (accessed on 6 May 2023).
- Girotto, F.; Alibardi, L.; Cossu, R. Food waste generation and industrial uses: A review. Waste Manag. 2015, 45, 32–41. [Google Scholar] [CrossRef]
- Calcio Gaudino, E.; Colletti, A.; Grillo, G.; Tabasso, S.; Cravotto, G. Emerging Processing Technologies for the Recovery of Valuable Bioactive Compounds from Potato Peels. Foods 2020, 9, 1598. [Google Scholar] [CrossRef]
- Cravotto, C.; Grillo, G.; Binello, A.; Gallina, L.; Olivares-Vicente, M.; Herranz-López, M.; Micol, V.; Barrajón-Catalán, E.; Cravotto, G. Bioactive Antioxidant Compounds from Chestnut Peels through Semi-Industrial Subcritical Water Extraction. Antioxidants 2022, 11, 988. [Google Scholar] [CrossRef] [PubMed]
- Grillo, G.; Boffa, L.; Talarico, S.; Solarino, R.; Binello, A.; Cavaglià, G.; Bensaid, S.; Telysheva, G.; Cravotto, G. Batch and Flow Ultrasound-Assisted Extraction of Grape Stalks: Process Intensification Design up to a Multi-Kilo Scale. Antioxidants 2020, 9, 730. [Google Scholar] [CrossRef] [PubMed]
- Ravindran, R.; Jaiswal, A.K. Exploitation of Food Industry Waste for High-Value Products. Trends Biotechnol. 2016, 34, 58–69. [Google Scholar] [CrossRef]
- Chemat, F.; Vian, M.A.; Fabiano-Tixier, A.-S.; Nutrizio, M.; Jambrak, A.R.; Munekata, P.E.S.; Lorenzo, J.M.; Barba, F.J.; Binello, A.; Cravotto, G. A review of sustainable and intensified techniques for extraction of food and natural products. Green Chem. 2020, 22, 2325–2353. [Google Scholar] [CrossRef]
- Calcio Gaudino, E.; Grillo, G.; Tabasso, S.; Stevanato, L.; Cravotto, G.; Marjamaa, K.; Pihlajaniemi, V.; Koivula, A.; Aro, N.; Uusitalo, J.; et al. Optimization of ultrasound pretreatment and enzymatic hydrolysis of wheat straw: From lab to semi-industrial scale. J. Clean. Prod. 2022, 380 Pt 1, 134897. [Google Scholar] [CrossRef]
- An, Q.; Li, L.; Liu, Y.; Wang, S.; Yuan, Q. Bioplastic production from food waste: A review. J. Clean. Prod 2021, 290, 125586. [Google Scholar] [CrossRef]
- Tabasso, S.; Mariatti, F.; Grillo, G.; Boffa, L.; Tibaldi, P.S.; Cravotto, G. Sustainable Microwave-Assisted Aerobic Oxidation of Tomato Plant Waste into Bioaromatics and Organic Acids. Ind. Eng. Chem. Res. 2019, 58, 8578–8584. [Google Scholar] [CrossRef]
- Ferdeș, M.; Zăbavă, B.Ș.; Paraschiv, G.; Ionescu, M.; Dincă, M.N.; Moiceanu, G. Food Waste Management for Biogas Production in the Context of Sustainable Development. Energies 2022, 15, 6268. [Google Scholar] [CrossRef]
- Johnravindar, D.; Wong, J.W.C.; Dharma Patria, R.; Uisan, K.; Kumar, R.; Kaur, G. Bioreactor-scale production of rhamnolipids from food waste digestate and its recirculation into anaerobic digestion for enhanced process performance: Creating closed-loop integrated biorefinery framework. Bioresour. Technol. 2022, 360, 127578. [Google Scholar] [CrossRef] [PubMed]
- Sheldon, R.A. Green Chemistry: Principles and Case Studies. By Felicia A. Etzkorn. Angew. Chem. Int. Ed. 2021, 60, 513–1032. [Google Scholar] [CrossRef]
- Chemat, F.; Vian, M.A.; Cravotto, G. Green Extraction of Natural Products: Concept and Principles. Int. J. Mol. Sci. 2012, 13, 8615–8627. [Google Scholar] [CrossRef] [PubMed]
- Chemat, F.; Abert-Vian, M.; Fabiano-Tixier, A.S.; Strube, J.; Uhlenbrock, L.; Gunjevic, V.; Cravotto, G. Green extraction of natural products. Origins, current status, and future challenges. Trends Anal. Chem. 2019, 118, 248–263. [Google Scholar] [CrossRef]
- Verdini, F.; Calcio Gaudino, E.; Grillo, G.; Tabasso, S.; Cravotto, G. Cellulose Recovery from Agri-Food Residues by Effective Cavitational Treatments. Appl. Sci. 2021, 11, 4693. [Google Scholar] [CrossRef]
- Basak, S.; Annapure, U.S. The potential of subcritical water as a “green” method for the extraction and modification of pectin: A critical review. Food Res. Int. 2022, 161, 111849. [Google Scholar] [CrossRef]
- Shitu, A.; Izhar, S.; Tahir, T.M. Sub-critical water as a green solvent for production of valuable materials from agricultural waste biomass: A review of recent work. Glob. J. Environ. Sci. Manag. 2015, 1, 255–264. [Google Scholar] [CrossRef]
- Roger, A.S. Metrics of Green Chemistry and Sustainability: Past, Present, and Future. ACS Sustain. Chem. Eng. 2018, 6, 32–48. [Google Scholar] [CrossRef]
- Curzons, A.D.; Constable, D.J.C.; Mortimer, D.N.; Cunningham, V.L. So you think your process is green, how do you know?—Using principles of sustainability to determine what is green—A corporate perspective. Green Chem. 2001, 3, 1–6. [Google Scholar] [CrossRef]
- Roger, A.S. The E Factor: Fifteen years on. Green Chem. 2007, 9, 1273–1283. [Google Scholar] [CrossRef]
- Jimenez-Gonzalez, C.; Ponder, C.S.; Broxterman, Q.B.; Manley, J.B. Using the Right Green Yardstick: Why Process Mass Intensity Is Used in the Pharmaceutical Industry to Drive More Sustainable Processes. Org. Process Res. Dev. 2011, 15, 912–917. [Google Scholar] [CrossRef]
- Singh, B.; Singh, J.P.; Kaur, A.; Singh, N. Phenolic compounds as beneficial phytochemicals in pomegranate (Punica granatum L.) peel: A review. Food Chem. 2018, 261, 75–86. [Google Scholar] [CrossRef] [PubMed]
- Pienaar, L.; Barends-Jones, V. The Economic Contribution of South Africa’s Pomegranate Industry. Elsenburg J. 2021, 18, 57–64. Available online: https://journals.co.za/doi/pdf/10.10520/ejc-agriprob-v18-n4-a23 (accessed on 6 May 2023).
- Fahmy, H.A.; Farag, M.A. Ongoing and potential novel trends of pomegranate fruit peel; a comprehensive review of its health benefits and future perspectives as nutraceutical. J. Food Biochem. 2022, 46, e14024. [Google Scholar] [CrossRef] [PubMed]
- Panth, N.; Manandhar, B.; Paudel, K.R. Anticancer Activity of Punica granatum (Pomegranate): A Review. Phytother. Res. 2017, 31, 568–578. [Google Scholar] [CrossRef] [PubMed]
- Yunfeng, L.; Changjiang, G.; Jijun, Y.; Jingyu, W.; Jing, X.; Shuang, C. Evaluation of antioxidant properties of pomegranate peel extract in comparison with pomegranate pulp extract. Food Chem. 2006, 96, 254–260. [Google Scholar] [CrossRef]
- Qu, W.; Breksa, A.P., III; Pan, Z.; Ma, H. Quantitative determination of major polyphenol constituents in pomegranate products. Food Chem. 2012, 132, 1585–1591. [Google Scholar] [CrossRef] [PubMed]
- Malviya, S.; Arvind Jha, A.; Hettiarachchy, N. Antioxidant and antibacterial potential of pomegranate peel extracts. J. Food Sci. Technol. 2014, 51, 4132–4137. [Google Scholar] [CrossRef]
- Zhang, Z.; Han, X.; Shi, J.; Xu, X. Review: Extraction of natural antioxidants from the matrices of plant foods. J. Food Sci. Technol. 2018, 55, 387–399. [Google Scholar] [CrossRef]
- Benedetti, G.; Zabini, F.; Tagliavento, L.; Meneguzzo, F.; Calderone, V.; Testai, L. An Overview of the Health Benefits, Extraction Methods and Improving the Properties of Pomegranate. Antioxidants 2023, 12, 1351. [Google Scholar] [CrossRef]
- Minutolo, A.; Gismondi, A.; Chirico, R.; Di Marco, G.; Petrone, V.; Fanelli, M.; D’Agostino, A.; Canini, A.; Grelli, S.; Albanese, L.; et al. Antioxidant Phytocomplexes Extracted from Pomegranate (Punica granatum L.) Using Hydrodynamic Cavitation Show Potential Anticancer Activity In Vitro. Antioxidants 2023, 12, 1560. [Google Scholar] [CrossRef] [PubMed]
- Cano-Lamadrid, M.; Martínez-Zamora, L.; Castillejo, N.; Artés-Hernández, F. From Pomegranate Byproducts Waste to Worth: A Review of Extraction Techniques and Potential Applications for Their Revalorization. Foods 2022, 11, 2596. [Google Scholar] [CrossRef]
- Pan, Z.; Qu, W.; Ma, H.; Atungulu, G.G.; McHugh, T.H. Continuous and pulsed ultrasound-assisted extractions of antioxidants from pomegranate peel. Ultrason. Sonochem. 2012, 19, 365–372. [Google Scholar] [CrossRef] [PubMed]
- Magangana, T.P.; Makunga, N.P.; Fawole, O.A.; Stander, M.A.; Opara, U.L. Antioxidant, Antimicrobial, and Metabolomic Characterization of Blanched Pomegranate Peel Extracts: Effect of Cultivar. Molecules 2022, 27, 2979. [Google Scholar] [CrossRef] [PubMed]
- Hillis, W.E.; Swain, T. The Phenolic Constituents of Prunus Domestica. II—The Analysis of Tissues of the Victoria Plum Tree. J. Sci. Food Agric. 1959, 10, 135–144. [Google Scholar] [CrossRef]
- Giusti, M.; Wrolstad, R.E. Acylated anthocyanins from edible sources and their applications in food systems. Biochem. Eng. J. 2003, 14, 217–225. [Google Scholar] [CrossRef]
- Peri, C.; Pompei, C. Estimation of Different Phenolic Groups in Vegetable Extracts. Phytochemistry 1971, 10, 2187–2189. [Google Scholar] [CrossRef]
- Aimone, C.; Grillo, G.; Boffa, L.; Giovando, S.; Cravotto, G. Tannin Extraction from Chestnut Wood Waste: From Lab Scale to Semi-Industrial Plant. Appl. Sci. 2023, 13, 2494. [Google Scholar] [CrossRef]
- Sen, S.; De, B.; Devanna, N.; Chakraborty, R. Total phenolic, total flavonoid content, and antioxidant capacity of the leaves of Meyna spinosa Roxb., an Indian medicinal plant. Chin. J. Nat. Med. 2013, 11, 149–157. [Google Scholar] [CrossRef]
- Yemm, E.W.; Willis, A.J. The estimation of carbohydrates in plant extracts by anthrone. Biochem. J. 1954, 57, 508–514. [Google Scholar] [CrossRef]
- Brand-Williams, W.; Cuvelier, M.E.; Berset, C. Use of a free radical method to evaluate antioxidant activity. Food Sci. Technol. 1995, 28, 25–30. [Google Scholar] [CrossRef]
- Locatelli, M.; Gindro, R.; Travaglia, F.; Coïsson, J.D.; Rinaldi, M.; Arlorio, M. Study of the DPPH-scavenging activity: Development of a free software for the correct interpretation of data. Food Chem. 2009, 114, 889–897. [Google Scholar] [CrossRef]
- Santos, J.S.; Brizola, V.R.A.; Granato, D. High-throughput assay comparison and standardization for metal chelating capacity screening: A proposal and application. Food Chem. 2017, 214, 515–522. [Google Scholar] [CrossRef] [PubMed]
- Franken, N.; Rodermond, H.; Stap, J.; Haveman, J.; van Bree, C. Clonogenic assay of cells in vitro. Nat. Protoc. 2006, 1, 2315–2319. [Google Scholar] [CrossRef] [PubMed]
- Zin, M.M.; Anucha, C.B.; Bánvölgyi, S. Recovery of Phytochemicals via Electromagnetic Irradiation (Microwave-Assisted-Extraction): Betalain and Phenolic Compounds in Perspective. Foods 2020, 9, 918. [Google Scholar] [CrossRef]
- Hayat, K.; Abbas, S.; Hussain, S.; Shahzad, S.A.; Tahir, M.U. Effect of microwave and conventional oven heating on phenolic constituents, fatty acids, minerals and antioxidant potential of fennel seed. Ind. Crops Prod. 2019, 140, 111610. [Google Scholar] [CrossRef]
- Thani, N.M.; Kamal, S.M.M.; Sulaiman, A.; Taip, F.S.; Omar, R.; Izhar, S. Sugar Recovery from Food Waste via Sub-critical Water Treatment. Food Rev. Int. 2020, 36, 241–257. [Google Scholar] [CrossRef]
- Leonelli, C.; Mason, T.J. Microwave and ultrasonic processing: Now a realistic option for industry. Chem. Eng. Process. Process Intensif. 2010, 49, 885–900. [Google Scholar] [CrossRef]
- Siddique, I.J.; Salema, A.A.; Antunes, E.; Vinu, R. Technical challenges in scaling up the microwave technology for biomass processing. Renew. Sustain. Energy Rev. 2022, 153, 111767. [Google Scholar] [CrossRef]
- Makhafola, T.J.; Elgorashi, E.E.; McGaw, L.J.; Verschaeve, L.; Eloff, J.N. The correlation between antimutagenic activity and total phenolic content of extracts of 31 plant species with high antioxidant activity. BMC Complement. Altern. Med. 2016, 16, 490. [Google Scholar] [CrossRef]
- Hider, R.C.; Liu, Z.D.; Khodr, H.H. Metal chelation of polyphenols. Methods Enzymol. 2001, 335, 190–203. [Google Scholar] [CrossRef]
- Vieira do Carmo, M.A.; Girotto Pressete, C.; Marques, M.J.; Granato, D.; Azevedo, L. Polyphenols as potential antiproliferative agents: Scientific trends. Curr. Opin. Food Sci. 2018, 24, 26–35. [Google Scholar] [CrossRef]
- Mo, Y.; Ma, J.; Gao, W.; Zhang, L.; Li, J.; Li, J.; Zang, J. Pomegranate Peel as a Source of Bioactive Compounds: A Mini Review on Their Physiological Functions. Front. Nutr. 2022, 9, 887113. [Google Scholar] [CrossRef] [PubMed]
- Emam-Djomeh, Z.; Moghaddam, A.; Ali Yasini Ardakani, S. Antimicrobial Activity of Pomegranate (Punica granatum L.) Peel Extract, Physical, Mechanical, Barrier and Antimicrobial Properties of Pomegranate Peel Extract-incorporated Sodium Caseinate Film and Application in Packaging for Ground Beef. Packag. Technol. Sci. 2015, 28, 869–881. [Google Scholar] [CrossRef]
- Holley, R.A.; Patel, D. Improvement in shelf-life and safety of perishable foods by plant essential oils and smoke antimicro-bials. J. Food Microbiol. 2005, 22, 273–292. [Google Scholar] [CrossRef]
- Ferrazzano, G.F.; Scioscia, E.; Sateriale, D.; Pastore, G.; Colicchio, R.; Pagliuca, C.; Cantile, T.; Alcidi, B.; Coda, M.; Ingenito, A.; et al. In Vitro Antibacterial Activity of Pomegranate Juice and Peel Extracts on Cariogenic Bacteria. BioMed Res. Int. 2017, 2017, 2152749. [Google Scholar] [CrossRef]
- Alexandre, E.M.C.; Silva, S.; Santos, S.A.O.; Silvestre, A.J.D.; Duarte, M.F.; Saraiva, J.A.; Pintado, M. Antimicrobial activity of pomegranate peel extracts performed by high pressure and enzymatic assisted extraction. Food Res. Int. 2019, 115, 167–176. [Google Scholar] [CrossRef]
- García-Ruiz, A.; Bartolomé, B.; Martínez-Rodríguez, A.J.; Pueyo, E.; Martín-Álvarez, P.J.; Moreno-Arribas, M.V. Potential of phenolic compounds for controlling lactic acid bacteria growth in wine. Food Control 2008, 19, 835–841. [Google Scholar] [CrossRef]
- Rodríguez, H.; Curiel, J.A.; Landete, J.M.; de las Rivas, B.; de Felipe, F.L.; GómezCordovés, C.; Mancheño, J.M.; Muñoz, R. Food phenolics and lactic acid bacteria. Int. J. Food Microbiol. 2009, 132, 79–90. [Google Scholar] [CrossRef]
- Dahham, S.; Ali, M.N.; Tabassum, H.; Khan, M. Studies on antibacterial and antifungal activity of pomegranate (Punica granatum L.). Am.-Eurasian J. Agric. Environ. Sci. 2010, 9, 273–281. [Google Scholar]
- Ismail, T.; Akhtar, S.; Sestili, P.; Riaz, M.; Ismail, A.; Labbe, R.G. Antioxidant, Antimicrobial and Urease Inhibitory Activities of Phenolics-Rich Pomegranate Peel Hydro-Alcoholic Extracts. J. Food Biochem. 2016, 40, 550–558. [Google Scholar] [CrossRef]
- Keta, O.; Deljanin, M.; Petković, V.; Zdunić, G.; Janković, T.; Živković, J.; Ristić-Fira, A.; Petrović, I.; Šavikin, K. Pomegranate (Punica granatum L.) Peel Extract: Potential Cytotoxic Agent against Different Cancer Cell Lines. Rec. Nat. Prod. 2020, 14, 5326–5339. [Google Scholar] [CrossRef]
- Modaeinama, S.; Abasi, M.; Abbasi, M.M.; Jahanban-Esfahlan, R. Anti Tumoral Properties of Punica granatum (Pomegranate) Peel Extract on Different Human Cancer Cells. Asian Pac. J. Cancer Prev. 2015, 16, 5697–5701. [Google Scholar] [CrossRef]
- Asmaa, M.J.; Ali, A.J.H.; Farid, J.M.; Azman, S. Growth inhibitory effects of crude pomegranate peel extract on chronic myeloid leukemia, K562 cells. Int. J. Appl. Basic Med. Res. 2015, 5, 100–105. [Google Scholar] [CrossRef] [PubMed]
- Nasr, M.; Naeem, S.A.; El-Shenbaby, I.; Mohamed, F.M.A.; Mahmoud, S.M.; Abuamara, T.M.M.; Abd-Elhay, W.M.; Elbayoumy, F.M.A.E.; Elkot, A.; Shikhon, T.; et al. Pomegranate Seeds and Peel Ethanolic Extracts Anticancer Potentials and Related Genetic, Histological, Immunohistochemical, Apoptotic and Oxidative Stress Profiles: In vitro Study. J. Exp. Pharmacol. 2023, 15, 191–205. [Google Scholar] [CrossRef]

| Fraction | Percentage Composition (%) | |
|---|---|---|
| Fresh Matrix | Dried Matrix | |
| Water | 75.52 | 3.50 |
| Organic | 23.86 | 94.06 |
| Inorganic | 0.62 | 2.44 |
| DPPH· Inhibition | Cu Chelating Activity | |||
|---|---|---|---|---|
| Matrix | EC50 | Trolox eq. | EC50 | EDTA eq. |
| (µg/mL) | (mmolTE/gext) | (µg/mL) | (µmolEDTA/gext) | |
| F-PP | 2.30 ± 0.45 | 13.18 ± 2.58 | 88.60 ± 9.8 | 513.66 ± 58.8 |
| D-PP | 5.30 ± 1.45 | 5.72 ± 1.57 | 85.90 ± 13.6 | 529.81 ± 83.9 |
| D-PP | F-PP | |
|---|---|---|
| Dry yield (%) | 67.20 | 20.18 |
| TPC Yield (mgGAE/gMatrix) | 175.64 | 48.99 |
| Power Consumption (kW) * | 1.94 ** | 0.97 |
| Polyphenol Power Efficiency (W/mgGAE) | 11.07 | 19.72 |
| F-PP | D-PP | D-PP/NF | Hydroalcoholic Extr. | |
|---|---|---|---|---|
| SF | 0.646 | 0.074 | 0 | 0.274 |
| RME (%) | E-Factor | PMI | PME (%) | |
|---|---|---|---|---|
| Hydroalcoholic Benchmark |  | |||
| D-PP Scale-up | ||||
| D-PP Scale-up NF | ||||
Disclaimer/Publisher’s Note: The statements, opinions and data contained in all publications are solely those of the individual author(s) and contributor(s) and not of MDPI and/or the editor(s). MDPI and/or the editor(s) disclaim responsibility for any injury to people or property resulting from any ideas, methods, instructions or products referred to in the content. |
© 2023 by the authors. Licensee MDPI, Basel, Switzerland. This article is an open access article distributed under the terms and conditions of the Creative Commons Attribution (CC BY) license (https://creativecommons.org/licenses/by/4.0/).
Share and Cite
Grillo, G.; Capaldi, G.; Radošević, K.; Jakopović, Ž.; Markov, K.; Brncic, M.; Gallina, L.; Calcio Gaudino, E.; Cravotto, G. Unlocking the Bioactive Potential of Pomegranate Peels: A Green Extraction Approach. Antioxidants 2023, 12, 1796. https://doi.org/10.3390/antiox12101796
Grillo G, Capaldi G, Radošević K, Jakopović Ž, Markov K, Brncic M, Gallina L, Calcio Gaudino E, Cravotto G. Unlocking the Bioactive Potential of Pomegranate Peels: A Green Extraction Approach. Antioxidants. 2023; 12(10):1796. https://doi.org/10.3390/antiox12101796
Chicago/Turabian StyleGrillo, Giorgio, Giorgio Capaldi, Kristina Radošević, Željko Jakopović, Ksenija Markov, Mladen Brncic, Lorenzo Gallina, Emanuela Calcio Gaudino, and Giancarlo Cravotto. 2023. "Unlocking the Bioactive Potential of Pomegranate Peels: A Green Extraction Approach" Antioxidants 12, no. 10: 1796. https://doi.org/10.3390/antiox12101796
APA StyleGrillo, G., Capaldi, G., Radošević, K., Jakopović, Ž., Markov, K., Brncic, M., Gallina, L., Calcio Gaudino, E., & Cravotto, G. (2023). Unlocking the Bioactive Potential of Pomegranate Peels: A Green Extraction Approach. Antioxidants, 12(10), 1796. https://doi.org/10.3390/antiox12101796










